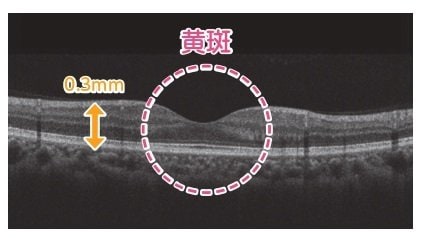
網膜の断層図

「緑内障」は早期発見が大事!日々進化する眼疾患の検査方法
眼科での検診を受けると、視力検査や眼圧検査のほかにも、目の内部を詳しく観察する検査を行います。
1つは「細隙灯顕微鏡(さいげきとうけんびきょう)検査」。
「暗くした室内で光を目に当てて、眼球の中を観察するものです。角膜、前房(ぜんぼう)、虹彩、水晶体、硝子体の状態を見ることができるので、炎症が起こっていないか、濁っていないかなどをチェックしていきます」
もう1つは「眼底(がんてい)検査」。
「こちらは目の“底”となる部分を見ていきます。網膜や、脳につながる視神経の束(視神経乳頭(にゅうとう))やカメラのフィルムに該当する網膜、その中でとくに大切な黄斑部(おうはんぶ)、血管の状態を見る検査です。視神経が弱くなっていないか、黄斑の構造は正常か、血管が狭くなっていたり、出血していないかなど様々な観察を行います」
この2つの検査は目の状態をチェックするのに欠かせないものです。これに加えて、網膜の状態をより詳しく検査する方法があります。
すべての画像を見る(全5枚)「『OCT検査(光干渉断層(ひかりかんしょうだんそう)検査)』という、網膜に近赤外線を照射して、その反射から網膜の断層図を作成する検査です」
「検査では、細かな網膜の状態を映し出すことができます。この検査によって、まだ視野欠損が始まる前の段階である「前視野(ぜんしや)緑内障」という初期段階の緑内障を見つけられるようになりました。無治療だと平均6年ほどで視野異常がでるとされているため、診断された時点で治療を始めることが多いです」